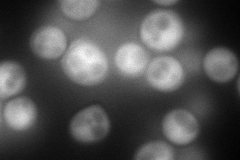
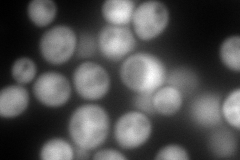
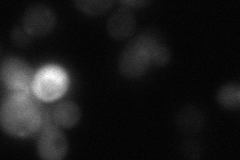
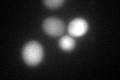
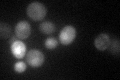

View description
Protein required for survival at high temperature during stationary phase; not required for growth on nonfermentable carbon sources
Localization:
Intensity:
Fold change:
Significance:
-
C’ GFP library in SD

cytosol27.77 -
N' NOP1pr-GFP in SD
cytosol211.089 -
N' TEF2pr-mCherry in SD
cytosol341.433 -
N' NATIVEpr-GFP in SD
cytosol28.3006 -
N' TEF2pr-VC and Cyto-VN in SD

cytosol62.9331 -
C’ GFP library in SD+DTT
cytosol37.341.34Yes -
C’ GFP library in SD+H2O2

cytosol47.161.69Yes -
C’ GFP library in Starvation Media
nucleusN/AN/AYes -
C’ GFP library on the background of Pup2-DaMP

cytosol -
C’ GFP library on the background of CCT mutant

cytosol17.9780.647333Yes
